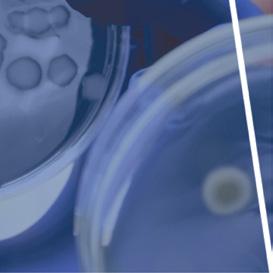
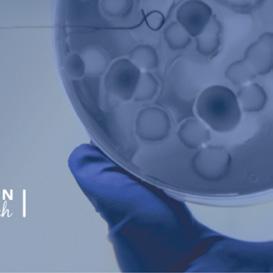
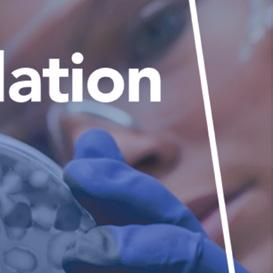
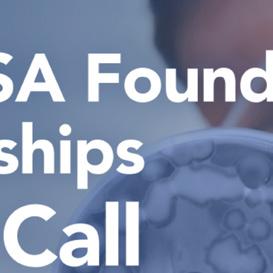
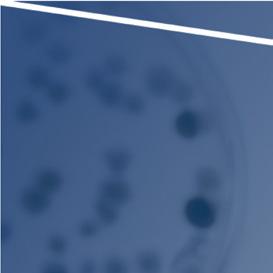

“I love everything about lateral thinking. Standardization bores me to death,” Christian Testoni says firmly. “Ever since I was a kid, I’ve loved sitting on a bench, watching passers-by, and coming up with stories about them. I first had a sense of true creative freedom when, one summer morning, I was looking at the sea. A boy walked past and I just decided to take a picture of him. I don’t know why (I would figure it out afterwards), but a sheep’s head suddenly popped into my mind and so I recreated it on the head of the boy.”

You would be forgiven for thinking that Christian was a photographer by profession; instead, he’s known for his voice and skills in producing radio programs and digital projects for the Italian language Swiss broadcasting organization RSI, demonstrating his limitless creativity and intriguing strength in innovation. He is a radio producer, father, avid reader of biographies, digital enthusiast, observer of the world, and artist. Christian Testoni is “one and a hundred thousand” souls and, only a few years ago, on the Romagna foreshore, far from mental diagrams and constructions, without even imagining it, he came up with the artistic and digital project: Andy Hood

“I liked that it wasn’t me. I wanted to give an instinctive, quick name to what would become the mother ship of my artistic identity. Andrea is the name I’d always wanted to give to one of my daughters: neutral, simple, and immediate: Andy . Hood has a more complex meaning, linked to the legend of Robin Hood and the concept that, culturally and historically, it continues to embody today. My greatest aspiration is to see my artworks quoted and recognized, so much so that they drive a machine capable of generating projects for the community, helping improve it. Giving back to people.”
The uniqueness of the Andy Hood projects lies in Christian Testoni’s ability to capture the ordinary elevated to the extraordinary, using objects from everyday life in an unexpected way, by intriguing and disrupting, challenging the viewer’s logic.
In the This is the Way project, for example, he does this by bringing the walls and urban streets of iconic cities such as Paris, London, and Milan into the spotlight, inserting figures and road sign symbols found in the surrounding environment, with a touch of humor and eccentricity. In his latest project Somebody - Digital Recycle Lab , he digitally assembles small human-like robots using common objects. Invisible, forgotten, ignored by many, but not by Testoni, who sparks the imagination and offers the public a new way of looking at our everyday world.
“I’m a great observer and I like listening, whenever I am at the bar or out walking around,” he says. “Sometimes I listen to stories told by family and friends. I look around and see objects, objects that are there but don’t mean anything to a lot of people. I stop to think and I realize that they have a story, that someone thought about them in that way, the architect who designed them, the craftsmen who made them, whoever decided to buy them and put them in that particular spot. I pick up my phone and I photograph them.”
Sometimes the images stay there for a while; sometimes inspiration strikes immediately and he gets to work on his characters. He smiles, looks up and admits that his project came about—he stretches his arms wide—”spontaneously.” It is the result of a free creative process that does not come from the need to please, to attract Likes, or follow established models. Nor has it been designed to sell or attract someone’s attention; it’s about free space and free creativity.



































































































We are a fast-paced society, often addicted to the technology that surrounds us, more victims of our phones than users of them. The digital world offers us incredible potential, but, as Christian says, “we never use it to the fullest, more often suffering, slaves of compulsively scrolling through our feeds, losing both the ability to get bored or to explore anything in depth.”
You want it because of a childhood memory or just because you like how it looks—that’s how you fall in love with a character, choose it and end up adopting it. The process doesn’t end with the purchase; a genuine process of buyer empowerment begins with this initial choice, as the purchaser is asked to choose a name, traits and a history for their character.
“I could do it, of course” Christian explains, “but the point is that the artwork is made by two people. I want it to be about sharing and not for the artwork to just be an end in itself, but about taking part. Everyone has a story to tell, about their dreams, passions, or desires; even someone who says they lead a dull life and aren’t creative, is.”
Andy Hood is a project that aims to use art to convey the importance of our own identity, the importance of knowing how to exploit digital tools and technology in an active way to create value, rather than being fed by an algorithm and content created by others.
Christian Testoni deliberately distances himself from standard communication, in search of honest dialog and discussion, putting people at the heart of every project.
Through this process Christian meets people, sparks discussions, helps them take off their mask and reveal their world. His is an art of taking part, in which the characters do plenty of different things, like starring in kids’ stories or appearing in the office’s most important picture.






























































































































Vulcander is the name of the character adopted by Florian Anderhub. It’s an outlandish name, with a hint of the mythological that elicits a smile. “This project immediately made an impression on me because it has much in common with an experience I often had as a child. Walking along the street, I used to stop and observe the fronts of cars, seeing something anthropomorphic in their shapes: some sad, others serious, still others almost seemed to be smiling. I imagined they were more than just cars, they had personalities, stories,” says Florian Anderhub, Chief Vision Officer at Ander Group. “It wasn’t easy to create my character, to decide on his name and personality. “We see it every day in our work, on a branding level, it’s not just about inventing a logo: we give an identity to a ser-
vice, a product, a person. Here, in the same way, we’re talking about creating a story, about giving the character an identity. I chose Vulcander because I wanted to create a direct link between the professional sphere and my childhood. Vulcander incorporates my name and the name of the agency, but also that vivid childhood memory, from back when I felt everything in life so powerfully.”
In Somebody – Recycle Lab , a bit like in Pirandello’s famous play, the characters come to life and fight for their existence and identity; they want to be represented and understand their role in the world, in search of an author that can complete and give meaning to their unfinished story.













 #109 VULCANDER
#109 VULCANDER
FOR SALE #11 PROTOTYPE

















#13 RAGNAR ROBOT




















































































FOR SALE #26 PROTOTYPE




# 28 DANGER












FOR SALE #35 PROTOTYPE





FOR SALE #48 PROTOTYPE
#52 SOUL





























































FOR SALE #60 PROTOTYPE
FOR SALE #63 PROTOTYPE
FOR SALE #88 PROTOTYPE
#90 ESPAIDINO






































FOR SALE #107 PROTOTYPE

FOR SALE #120 PROTOTYPE
FOR SALE #86 PROTOTYPE #124 ZUCCO





FOR SALE #137 PROTOTYPE


FOR SALE #144 PROTOTYPE
FOR SALE #148 PROTOTYPE



FOR SALE #155 PROTOTYPE
FOR SALE #170 PROTOTYPE
FOR SALE #189 PROTOTYPE
FOR SALE #205 PROTOTYPE
FOR SALE #255 PROTOTYPE

FOR SALE #268 PROTOTYPE


FOR SALE #276 PROTOTYPE





































Art. Technology. Storytelling. Florian Anderhub was bound to identify with these cornerstones of Christian Testoni’s project. And if we weave in the common thread with his childhood, Florian has a special place in his heart for “the world of Andy Hood”. Which is why he decided to gift his friend Christian Testoni an authentic digital showcase, providing Ander Group’s resources for the development of an ecosystem that would allow the art to thrive.
Andy Hood’s works, sold as NFTs, have found their place in an interconnected landscape where the capabilities of HubSpot and Shopify are combined. The result is a smooth transition between the two platforms, offering users a seamless experience: switching between the website and the online shop is by no means an abrupt change, but a natural step.


Christian Testoni’s creative identity emerges through the theme of space, which evokes the idea of “travel” through the world of NFTs and the Andy Hood universe. We used vibrant acid green, a color that is inextricably linked to the theme of digital art, to symbolize innovation and progressiveness.
The ecosystem that we developed not only provides users with a seamless experience, but also helps boost the visibility of the art itself thanks to HubSpot’s ability to optimize

search engine indexing. The Verisart plugin, which we selected on the Shopify marketplace, allows NFTs to be purchased both with crypto and by credit card. The application also ensures anchoring on the blockchain, which identifies the digital artwork as unique and no longer available for purchase. Once again, the process is streamlined and in line with the website and shop features, allowing users to enjoy the “fine art” of purchasing artwork.


























Purchase authentic, blockchain-backed NFT masterpieces and redefine the concept of ownership. Visit andyhood.art




“A character, sir, can always ask a man who he is. Because a character truly has a life of his own, marked with his own characteristics, which always makes him ‘somebody’. While a man—I’m not saying you at this moment—a man in general, can be ‘nobody.’”
Luigi Pirandello
PUBLISHER
Ander Group SA

Via Cantonale 4
CH-6928 Manno

T +41 91 966 99 66
wanderful@ander.group www.wanderfulmag.ch
EDITOR IN CHIEF

Francesca Moretti
CREATIVE DIRECTOR
Luciano Marx
CONTRIBUTING EDITORS


Michele Cristiano, Paolo Domenighetti, Gloria Farris
Centro Stampa Ticino SA, Muzzano
COVER Andy Hood: for sale #16 prototype
© 2023 Ander Group
Welcome to the 21 st edition of our Wanderful Mag!
It’s our philosophy to reveal the “wanderful” things all around us: outstanding businesses and projects, often unknown yet remarkable all the same. In light of this, I wanted to dedicate some space to someone dear to me, an old acquaintance called Christian Testoni. The piece is a reflection on the concept of identity, self-knowledge and the capacity for listening and storytelling. Essential factors for the individual, but equally important in business.
Editorially, then, we have decided to tell our own story, revealing the dynamism that sets us apart and that led us to think about our own rebranding, defining our fundamental pillars and that which differentiates us from a traditional agency: our method –Performance Branding.
We’ve given this, our 21 st edition of Wanderful, a new layout: four features that you’ll find highly engaging and that focus on extremely topical issues through our methodology.
“Business Lifestyle” deals with corporate themes, from new trends such as NFTs and generative AI, to Switzerland’s cutting edge and its digital transformation. “Market Insight” takes us into the world of Non-Profit organizations, particularly focusing on foundations in Switzerland. “Success Stories” offers concrete examples of company results, and, finally, “Growth by Design” is the section closest to our heart, all about Business Growth Assurance. We also have hot news on our technological partner Goodcode, opening the way to new horizons and new possibilities…but no spoilers here!
In this edition, I simply ask you to let all that is Wanderful inspire you.
Florian Anderhub Chief Vision Officer Ander Group
The most significant case studies. Examples of how growth occurs when different experiences, ideas and skills are shared and pooled together.
A feature all about our signature methodology, aimed at ensuring company growth and at meeting long-term strategic goals.

Back in 2014, Kevin McCoy did something quite groundbreaking. He created the world’s first nonfungible token (NFT) and minted on Namecoin blockchain naming it “Quantum”. In 2021 the work was sold by auction at Sotheby’s for a mind-blowing $1.47 million. Since then, NFTs have exploded in popularity, particularly in the context of fine art collecting.
But it’s not just about art anymore. NFTs have become a total game-changer, shaking things up in a wide range of industries. They’ve sparked a digital revolution, breaking all the rules and pushing boundaries. Suddenly, the whole concept of ownership and scarcity in the digital world has taken a dizzying turn. Thanks to these extraordinary tokens, digital assets now hold value, uniqueness,
and verifiable ownership. And now, artists, musicians, athletes, and even big brands have all jumped on the NFT train, using it as a cool and innovative way to connect with their audience, invest, and establish direct relationships with collectors and fans. It’s a whole new world and it’s playing out right before our eyes.
Recommended reading
Il capitale decentralizzato. Blockchain, NFT, Metaverso (Decentralized capital: Blockchain, NFTs, Metaverse)

Pierangelo Soldavini, Journalist at Il Sole 24 Ore, and Frank Pagano, Senior Partner at Jakala and Shareholder at Tokenance, with the collaboration of Paolo Domenighetti CEO of Goodcode, delve into the world of blockchain, probing its impact in different contexts such as NFTs, cryptocurrencies, decentralized finance and more. In this incisive investigation, the authors explore the revolutionary potential of Web3, revealing scenarios for change and innovation.

An NFT acts as a digital certificate of ownership for a specific digital item, which goes beyond just artwork and applies to a whole array of digital assets. Here’s how it works in a nutshell. An NFT is a unique series of computer code that holds essential information about the digital item it represents, which could be anything from virtual real estate to collectibles, music, videos, or even intellectual property. In simpler terms, an NFT is like a digital badge that says, “Hey, this specific digital item belongs to this person.” So that’s the gist of it. NFTs provide a means to establish unique ownership and verify the authenticity of various digital assets, allowing individuals to assert their rights and engage with their audience or community in novel ways.
NFTs rely on blockchain technology and primarily reside on the Ethereum blockchain, accessible to individuals worldwide, which acts as a transparent and secure ledger for verifying and recording ownership. With NFTs, creators can tokenize their digital creations, such as artwork, videos, or virtual items, and sell them as unique pieces.
When we talk about a digital resource, it’s usually assumed that it can be easily copied and shared endlessly. For example, you can make copies of a file and store it on multiple devices or transfer it across the internet without any noticeable difference from the original. However, with the rise of NFTs, a new concept has emerged: “verifiable digital scarcity.”
Here’s the secret: hashing algorithms. These algorithms create a special code, or hash, for each digital file. The hash remains unchanged unless the contents of the file are altered. By putting that hash into an NFT, creators and collectors can prove who owns the original and make sure it’s the real deal.
NFTs are turning the art scene upside down, giving artists the power to prove the authenticity of their digital masterpieces. They act as a sort of seal of approval, putting an end to doubts about authenticity. And there’s very good news for artists, who can now earn a slice of the pie whenever their digital creations are sold or resold, setting up a perpetual reward.
But that’s not all. NFTs break down barriers and empower artists to connect directly with their fans and collectors. No more middlemen or gatekeepers standing in the way. It’s like having a virtual studio where the community can gather and celebrate artistic brilliance.
Another plus is that NFTs transcend borders, allowing art to reach enthusiasts across the globe. Gone are the days of worrying about shipping physical pieces or securing gallery spaces.
It’s like hosting an everlasting art exhibition that’s accessible to anyone, anywhere, anytime.
Beyond the art world, NFTs have a whole other universe of applications. We’re talking about establishing ownership, authenticity, and uniqueness for all sorts of digital products. Let’s take a look at some examples on page 25.
While traditional money in your bank account drives everyday purchases, cryptocurrency steals the spotlight when it comes to transactions on the blockchain. With crypto at your fingertips, you have the freedom to obtain or convert it into a fiat currency or other cryptocurrencies through crypto exchanges.
This gives them the power to show off their creations, stop people from copying them, and make their digital creations truly unique.
Prompt: exhibition featuring paintings placed within a Salvador Dalí or Giorgio de Chirico landscape.

The world of NFTs extends far and wide, presenting a multitude of opportunities (and some challenges as well!) across diverse industries. Trying to understand the complexities of this emerging landscape can be daunting, especially for newcomers. However, there’s no need to worry. To navigate this ever-changing digital scenario with confidence, it’s advisable to partner with professionals who possess a deep understanding of this field. With their guidance, you can fully embrace the boundless opportunities and unleash the true potential of NFTs.
While NFTs open up new frontiers in the digital world, there are some bumps along the road and it’s important to balance the hype with some real talk.
One key consideration is the environmental impact of NFTs. The blockchain technology underpinning NFTs consumes a hefty chunk of energy, raising valid concerns about sustainability and carbon emissions. Fear not, though, as efforts are being made to address these issues and find more energy-efficient solutions.
Another consideration is the potential for market saturation and the devaluation of digital assets. With the ease of minting and trading NFTs, there is growing concern about the flood of digital content and its impact on the value and scarcity of individual assets. Finding ways to maintain the uniqueness and exclusivity of NFTs will be crucial in sustaining their value.
Lastly, there is a need for user education and awareness regarding the technical aspects of NFTs. Understanding how to safely store and manage NFTs, including the use of crypto wallets and secure platforms, is crucial to prevent loss or theft of digital assets. •
“At Goodcode, we develop projects offering a detailed assessment of the potential for exploiting NFTs and blockchain technology. We offer all-round consultancy, including: choosing the ideal blockchain, tokenization, developing smart contracts, creating wallets and content digitalization, proposing bespoke solutions for our customers’ specific needs.”
Paolo Domenighetti Chief Executive Officer Goodcode
Real Estate
NFTs can revolutionize the real estate industry by digitizing property ownership and streamlining transactions. Properties can be represented as unique NFTs, allowing for transparent and efficient buying, selling, and transferring of ownership.
Fashion and Luxury Goods
NFTs can authenticate and track the provenance of high-end fashion items and luxury goods. Each product can be associated with a unique NFT, providing a verifiable record of authenticity, ownership, and potentially enhancing resale value.
Intellectual Property NFTs offer a new way to protect and monetize intellectual property rights. Musicians, writers, and content creators can tokenize their work as NFTs, establishing ownership, licensing, and royalty agreements in a transparent and automated manner.
Sports Memorabilia and Collectibles
NFTs have made significant strides in the sports world, allowing fans to own and trade digital collectibles such as virtual trading cards, highlight clips, and limited-edition merchandise. These digital assets can have real value and can be bought, sold, and traded securely using blockchain technology.
Supply Chain and Product Authenticity
NFTs can be used to verify the authenticity and traceability of products throughout the supply chain. From luxury goods to pharmaceuticals, NFTs can ensure the integrity of products, reduce counterfeiting, and give consumers greater confidence in their purchases.
Finance
Traditional finance is shifting to blockchain, companies are beginning to digitize, and asset tokenization is becoming common practice. Explore the topic on page 34
Digital transformation has been part and parcel of Ander Group’s projects from day one. And by 2016 we needed an in-house unit dedicated to software development and digital solutions, on hand to cater to our clients’ specific requirements. That’s why we set up Goodcode GmbH.
The efforts and hard work put in since then have helped Goodcode secure a prominent position on today’s market, enabling it to set itself a new growth milestone: the takeover of Snippet 4.0 Sagl, a DOS Group SA subsidiary.
DOS Group operates in the field of software development and owns Habilis, the virtual training management platform used by all ambulance organizations in the Canton of Ticino. In Goodcode, it has found a technology partner that can oversee all its development projects and in particular VR technology management, which became necessary following the sale of the Momentum software and dedicated resources to SureVIVE.


The new corporate structure will involve a capital increase and transformation into a joint stock company (Goodcode SA), with entry into the shareholding structure of DOS Group SA.
With this operation, Goodcode aims to become Ticino’s leading software house, serving a wide range of institutional and private customers by combining app and software development with expertise in the fields of AI, machine learning, cybersecurity, Web3 and systems integration. Meanwhile, DOS Group is wrapping up its refocusing process on its core business in the ICT sector, which it has built up over the last 20 years thanks to partnerships in Switzerland and beyond.


The new board of directors will include key figures like Florian Anderhub (Chief Vision Officer - Ander Group SA), Stefano Doninelli (Chairman and Head of Innovation – DOS Group SA) and Alessandro Cavadini (Business Consultant –Celio Cavadini & Partners).
“Goodcode’s philosophy, ‘Development is Good’, has been our guiding light on the path to excellence from the outset. In this exciting new phase, partnering up with DOS Group and taking over Snippet 4.0 Sagl and its customer base will give us the opportunity to work on new projects, capitalizing on our skills with premium institutional customers.”
Paolo Domenighetti, Goodcode Co-Founder and CEO
Generative AI has become our go-to companion, effortlessly handling our daily needs in both our personal and professional lives. Thanks to incredible tools like ChatGPT and Midjourney, we’re experiencing a whole new level of convenience and efficiency, bringing countless benefits to the table.

Think about the way we use these tools at home. They act as smart virtual assistants, organizing our schedules, suggesting recipes for a special dinner, answering our questions, and even keeping us entertained with personalized content. And in the business world? They’re like supercharged productivity boosters, generating top-notch content or
graphics, providing personalized recommendations, analyzing data, and delivering interactive experiences. The rise of generative AI highlights its transformative power in meeting our everyday demands, making life smoother and more enjoyable, both in and outside the office.

While generative AI is transforming the world one algorithm at a time, companies are confronted with a critical question: Is this technology merely a fleeting trend or a truly transformative breakthrough with immense potential for their businesses? Pondering the answer, CEOs seek to discern the inherent value that generative AI brings to their organizations.

According to Gartner – an American technological research and consulting firm based in Stamford, Connecticut that conducts research on technology – the future of generative AI will be nothing short of extraordinary. While the initial hype surrounding generative AI may fade as the practical implementation takes center stage, its true potential will continue to unfold as individuals and businesses unlock innovative applications that revolutionize our daily work and life.
This technology builds upon significant advancements, including generative adversarial networks and large language models with trillions of parameters. By leveraging these developments, data scientists can train models with vast amounts of data, offering several benefits for businesses. Among the increasingly prevalent applications that are gradually becoming part of our daily routines, some stand out:
The Rapid Content Creation: one of the most immediate advantages of generative AI is its ability to create content on the fly. According to Arun Chandrasekaran, Vice President and Analyst of Tech Innovation at Gartner, this capability provides tangible value today, enabling businesses to generate marketing newsletters, blogs, and other forms of content efficiently.
on general descriptions. This comprehensive approach takes chatbot interactions to a whole new level of excellence, ensuring exceptional customer service outcomes.
Let’s Talk About Personalization: generative AI has the potential to improve anyone’s efforts in this area. By analyzing user behavior and purchasing history, machine learning algorithms can generate personalized product recommendations and create custom content tailored to individual preferences.
But it doesn’t stop there. Future applications show even greater potential and are set to make long-lasting impacts across all industries. In the medical field, for instance, we can expect groundbreaking developments with predictive medical images that will revolutionize diagnosis and treatment planning by predicting the future progression of diseases.
More specifically, it allows users to fine-tune text tone, adapting language style to different contexts, whether informal or professional, and adding a personalized touch. It provides concise summaries of extensive conversations, articles, emails, and webpages, enabling faster information absorption and decision-making. It streamlines complexity, breaking down intricate content into simpler formats, such as by creating outlines or extracting key information, facilitating comprehension and knowledge transfer. Also, it efficiently categorizes content based on criteria like sentiment analysis and topic categorization, promoting the streamlined organization and retrieval of information.
An Enhanced Customer Experience: generative AI is revolutionizing customer interactions, enabling chatbots to function as highly intelligent virtual assistants that seamlessly blend into human-like conversations. These advanced chatbots, powered by sophisticated language models, provide personalized and comprehensive assistance that exceeds customer expectations. However, their capabilities go beyond passive support. These bots actively collaborate with customer service agents to deliver unparalleled assistance. By closely monitoring conversations, they seamlessly integrate into the process, offering relevant resources and insights. Additionally, generative AI enhances chatbot performance by improving sentiment extraction accuracy, classifying sentiments across entire conversations, and generating conversational flows based
Prompt: predictive medical image that revolutionize diagnosis and treatment planning by showcasing the future progression of diseases.

Gartner predicts that by 2025, 30% of large organizations’ outbound marketing messages will be synthetically generated, compared to a mere 2% in 2022.Source: Gartner 2023 on generative AI
Did you know that AI-powered ChatGPT and Bing’s Chatbot can already pass the bar and medical licensing exams, including essay sections? On IQ tests, they score in the 99th percentile – i.e., genius level.
Another exciting application is the utilization of synthetic data, which supplements limited datasets, mitigates bias, protects data privacy, and enables simulations of future
scenarios, driving advancements in various fields. Additionally, it plays a pivotal role in modernizing legacy code, transforming it to meet contemporary software standards, optimizing performance, security, and long-term maintainability.
These emerging use cases present boundless possibilities and hold the potential for transformative advancements that will have profound and lasting effects across diverse industries and domains.
Generative AI is set to shake up various industries, from pharmaceuticals, manufacturing, media, and architecture to interior design, engineering, automotive, finance, aerospace, defense, medical, electronics, and energy. By infusing AI models into core processes, generative AI will

Predictive medical images will revolutionize diagnosis and treatment planning by predicting the future progression of diseases.
increase efficiency and productivity across these sectors. But its influence won’t stop there. It will also make waves in areas like marketing, design, corporate communications, training, and software engineering, where generative AI will revolutionize support processes that span multiple organizations.
By 2025, according to Gartner’s prediction, over 30% of newly developed drugs and materials will be discovered through systematic use of generative AI techniques, a remarkable shift from the current scenario of zero utilization.
The potential of generative AI in the pharmaceutical industry is truly promising, offering significant opportunities to slash costs and accelerate the drug discovery process.
Yes, indeed! First and foremost, we have the application of generative AI in product development: the ability to fast-track innovation and create novel products that will leave competitors far behind, whether it’s a groundbreaking pharmaceutical discovery, an environmentally friendly solution or the latest technology product that will change people’s lives. As companies strengthen their AI capabilities, they unlock new revenue channels, propelling them ahead of competitors and positioning themselves at the forefront of industry innovation. Not least, by improving
employees’ work performance: generative AI enhances teams’ ability to effortlessly draft, edit, and refine various forms of media. This technology goes beyond mere automation, as it can also summarize, simplify, and classify content, generate, translate, and verify software code, and even elevate chatbot performance. At this stage, generative AI is highly proficient at rapidly creating a wide range of output on a scalable level. Moving on to long-term talent optimization, employees will stand out for their exceptional ability to conceive, execute, and refine ideas, projects, processes, services, and relationships in collaboration with AI. This symbiotic relationship accelerates their time to achieve proficiency and significantly expands the range and competency of your workforce across the board. By embracing this technology, teams become an unstoppable force, pushing boundaries, and achieving heightened levels of innovation. Furthermore, process improvement takes center stage with generative AI. Its remarkable capability to extract genuine, contextually relevant value from vast content repositories that may have previously gone untapped heralds a transformative shift in workflows. Businesses will witness a revolution in how work is performed as generative AI unlocks untapped resources, providing valuable insights and actionable information that can drive an organization’s success.
The advent of generative AI signals the start of a promising era. Enthusiasm surrounding this technology is tangible, and initial trials are fascinating. However, fully unlocking the potential benefits of generative AI will require patience as leaders in various sectors deal with significant challenges. These include effectively managing the inherent risks associated with generative AI, anticipating and acquiring

the necessary skills and competencies for the workforce, and fundamentally reimagining core business processes to encompass vital aspects like skill development and retraining.
To effectively navigate the integration of AI into their operations, businesses must take into account various critical factors. First and foremost, conducting a thorough evaluation of available data sources becomes necessary to provide AI models with access to pertinent and high-quality data. Equally vital is the selection of an appropriate AI technology or platform that aligns with the company’s unique requirements and objectives. Additionally, the development, testing, and fine-tuning of AI models necessitate an iterative approach, while continuous monitoring and maintenance are essential to uphold accuracy and efficacy over time.
Business growth is based on finding a balance between brand positioning, performance marketing and process automation. Through “augmented consultancy” – a new development in corporate consultancy – we integrate all these dynamics, taking advantage of the technology and enabling companies to achieve their maximum digital potential by developing human capabilities.
In the modern age, every operation involves the generation of new data. Companies with a data-driven approach can better understand their customers, identify areas for improvement and seize hidden market opportunities.
By integrating AI-driven solutions, organizations can optimize their processes, enhance customer experiences, and unlock new revenue streams. However, in recognizing the complexity of this endeavor, it is crucial to rely on professional partners who can offer guidance and expertise, assisting in navigating the potential challenges and difficulties that arise throughout the AI integration journey. •
“Every day, companies find themselves faced with the challenge of collecting, transforming, protecting and analyzing data. It is here that the latest technologies come into play, such as artificial intelligence and machine learning, to manage the huge volumes of data and extract useful insights from them for businesses. A major focus of my work is the organization of data, together with database design and integration. Thanks to qualitative and quantitative analysis, I can offer customers a clear perspective and a bespoke optimized strategy with measurable results.”
Michele Cristiano Data Science Engineer Ander Group
Digital transformation is no longer a luxury; it has become a survival imperative for businesses across all sectors, with AI playing a central role in this process by enabling companies to harness the power of data and turn it into actionable insights.
As companies strengthen their AI capabilities, they unlock new revenue channels, propelling them ahead of competitors and positioning themselves at the forefront of industry innovation.
Prompt: futuristic poker chips on a white background.





The evolution of the digital economy has led to the concept of tokenization, which is revolutionizing how businesses manage their assets. Tokens1 provide a new level of exchange within the blockchain2, going beyond cryptocurrencies (digital value units designed to work exclusively on the blockchain infrastructure), with significant benefits for companies. Technically speaking, the tokenization of assets means creating a computer code that captures the key elements of the asset, while at the same time offering a means of interacting with its digital version (digital twin). The process requires no intermediaries, and no time is wasted!
To understand how asset tokenization works, we must first understand the role that smart contracts play in transforming an actual asset into its digital version. The conditions of the contract between the parties are translated into code and added to the blockchain network; this means that a smart contract is executed automatically. Based on the computational logic If This Then That (ITTT), the tokens can be delivered directly to investors, when the contractual conditions are met, by means of the smart contract. The process provides transparency, precision and
efficiency, thanks to the public availability of contractual terms and historical data.
But blockchains and smart contracts don’t have direct access to information in the outside world. So, if they were based only on the information available on their network, their use would be extremely limited. Their scope and reach can be extended by “oracles” that obtain and validate external sources, allowing to see the outcome of smart contracts and, when added to a blockchain (decentralized), provide even greater reliability, security and transparency.
Returning to the game analogy, let’s imagine a bet, which is subject to a smart contract, made between two people on an external event, such as a sports match or a horse race. The information on the winner isn’t available directly on the blockchain, but can be obtained by an external entity, the “oracle”.
The oracle plays a crucial role here: as a reliable intermediary, it retrieves and validates the result of the game in question. Once it gets the result, the oracle transmits it to the smart contract, thus authorizing it to pay the bets. This mechanism ensures that the outcome of the bet is reliable and transparent, since the result is confirmed by an external, independent and verifiable entity.
1 Token: a set of digital information on a blockchain that confers a right of ownership upon a particular individual and has a precise value only within a well-defined context. They can be thought of as analogous to casino tokens or chips, i.e., pieces assigned a recognized value only within the context where they can be used.
2 Blockchain: referring to a “chain of nodes”, a blockchain is a computer-based technology that securely and unequivocally manages a public ledger (a type of digital register), comprising a series of data and information, that certifies transactions and allows them to be tracked. It functions in a decentralized environment that is accessible to all and requires no supervising central authority. Blockchain technologies are an integral part of the vast family of Distributed Ledger Technology (DLT), comprising systems based on distributed ledgers that can be read and edited from multiple nodes within a network. With no central authority, the nodes (computational accounts that track the transactions) must reach an agreement in order to validate the changes made to the ledger. The blockchain thus has three features: transparency, immutability and decentralization.
As technology advances, it opens up new possibilities for those who are ready to take the next great leap forward: to become genuine digital businesses, putting all they’ve got on the table (or on the blockchain!), like a bold “all-in” in a poker game.
Switzerland has established itself decisively as a global pioneer in blockchain technology and cryptocurrencies. Its excellent regulatory environment, combined with a stable political climate and robust financial infrastructure, has made Switzerland an attractive destination for blockchain start-ups and investors. The first major step in this direction came on February 1, 2021, an historic day for the country, when the new DLT Act was introduced, paving the way for the concept of “tokenized shares”.
Today we are witnessing a major change: the rapid transfer of traditional finance “on-chain”
Both the Swiss federal government and the Swiss Financial Market Supervisory Authority (FINMA) are fully aware of the tremendous potential of the blockchain and of DLT technology within financial services and in various other sectors of the economy.
At a national level, the founding of the Crypto Valley Association in Zug, the proliferation of numerous blockchain companies, and the various initiatives linked to this technology are not to be overlooked. This has led to the development of futuristic, innovative and ambitious projects such as Lugano’s Plan , where the city and Tether, the company behind the world’s most widely used stablecoin, signed a strategic agreement in March 2022 to strengthen the city’s global positioning as a blockchain and cryptocurrency hub. The goal is to accelerate the use and exploitation of blockchain technology to transform the city’s financial infrastructure.
Promoting itself as a model of innovation, Lugano, in partnership with the Zürcher Kantonalbank, has granted a debenture loan wholly based on Distributed Ledger Technology, through the innovative SIX Digital Exchange (SDX) platform. Associated with the SIX Group, this is the world’s first fully regulated digital platform based on Distributed Ledger Technology.
01/12/2023
Lugano had previously launched its own payment token (the LVGA), an alternative form of digital payment, with the purpose of encouraging spending in the city and supporting local trade. This token is based on blockchain technology that certifies its transactions.
While Zug benefits from a strong fiscal attractiveness, the initiative in Lugano is focused rather on real use cases, on the presence of a growing community of experts in the city and on training programs. In classic Swiss style, there are several competing companies in the blockchain field seeking to offer businesses and individuals the best possible operating conditions.
All of this indicates that Switzerland, and cities like Lugano in particular, are determined to establish themselves as global leaders in the field, eagerly embracing the new developments and with officials and authorities that are always open to explore the latest innovations.
This is the first debenture loan in the history of the public sector to be granted, listed and negotiated digitally on a regulated platform based on blockchain technology. Press release, Lugano,
“Switzerland has a thriving ecosystem at the forefront of innovation that brings multinationals, large financial institutions and start-ups under one roof. If you are looking for a regulated, approachable environment, Switzerland is a good place to start.”
Alexander Brunner, President of HomeOfBlockchain.swiss





“It’s inevitable that what we’re doing in Lugano will also be of interest to the world of finance. Digital technologies, including the blockchain, are the facilitators of major ongoing changes. Lugano aims to be one of the pioneers of such changes and to foster a positive transformation, an ‘upcycling’ of the financial center.”
Michele Foletti, Mayor of Lugano
Switzerland’s DLT legislation permits countless blockchain implementations, including making corporate shares liquid, and opening up the capital market for small and medium-sized enterprises. SMEs can now raise capital from qualified investors using blockchain technology through much less onerous processes. This unique opportunity makes it possible to accelerate the expansion of businesses, providing them with a more efficient avenue for obtaining financing.

A company like Aequitec, for example, has an innovative software solution for non-listed companies and enables SMEs to digitize their share register using a blockchain and to raise capital by issuing native security tokens, both in fiat and crypto denominations. For instance, employees can book shares in their bank deposits and strengthen their bond with the company.
Berner Kantonalbank AG (BEKB), for example, has developed a platform for trading and custody of tokenized assets. The marketplace for trading securities that are transferable as token has been ready under the name SME|X since December 2021.
Transforming assets into tokens has many advantages that accelerate and optimize operations, bringing greater efficiency and fluidity to the exchange process. In addition, entry on the blockchain involves moving from the private to the public domain, thus enabling a more accurate assessment of the asset’s value.
One of the main benefits of tokenization is a wider access to investors from all over the world, crossing geographic borders and offering investment opportunities to a broader public. Subdividing assets enables several people to own a part of the asset, encouraging micro-ownership. Not only does this raise the brand’s profile, it also enables a wider public to make investments and diversify portfolios. It also improves economic efficiency. Reduced brokerage costs facilitate a more efficient transaction management, while the automation and elimination of intermediaries reduces execution times. Furthermore, the smart contracts that regulate tokens can be programmed to reward stakeholders for their virtuous behavior, creating an additional incentive for them to make a positive contribution.
Tokenization is becoming an unstoppable trend that clearly points to the future. This transformation opens up new opportunities for efficiency and for access to financial markets, promoting a more open, decentralized and inclusive system. To deal successfully with the associated challenges, it’s vital to turn to expert professionals who are able to provide full support with corporate digitalization.
Goodcode GmbH has extensive expertise in the field of blockchain technology, safe custody of documents, KYC (Know Your Customer), the building of oracles and escrow agreement services, as well as tailor-made smart contracts. It’s not enough to simply embrace digital: becoming a digital company is the real issue at stake. Strategic partnerships will enable you to move safely in the tokenization sphere, playing your best hand and fully reaping the benefits offered by this revolutionary technology.
Nonetheless, the underlying blockchain technology means that all stakeholders have the ability to carry out comprehensive audits on every aspect of the platform, ensuring greater transparency and shared control. While there are no particular limitations to what can be tokenized, these are a few examples: corporate or personal assets (property, documents, company balance sheets), shares, and investment funds (securities).
Assets and shares can therefore be transferred electronically without the need for signed paper documents or intermediaries such as banks or professional custodians. This process significantly simplifies the sale of shares to investors and offers issuers a straightforward way of accumulating capital. Unlike digital tokens issued through Initial Coin Offerings (ICO), which incorporate tailor-made contractual rights with regard to the issuer, tokenized shares have the benefit of being financial tools that investors find familiar. Since they are governed by a clear legal framework, investors are able to understand them quite easily. •
“At Goodcode and Ander Group, we are in the process of digitalizing and tokenizing our shares, what about you?”
Paolo Domenighetti Chief Executive Officer Goodcode
As well as improving efficiency and liquidity, it also reduces the red tape associated with the process.
“It can be argued that we are at the dawn of a development similar to the introduction of the joint-stock company and the opening of the first stock exchange in 1602.”
Ilsole24ore
Switzerland, often referred to as the “Land of Precision”, has long been recognized for its remarkable achievements in various fields. However, like many countries, Switzerland faces its own set of challenges, particularly in the realm of digitalization, and now, Switzerland finds itself at a crossroads, where staying ahead of the game means embracing lightning-fast technological advancements.
Estimates suggest that embracing digital transformation can bring about a much-needed productivity boost of around one percentage point annually until 2030 (McKinsey&Company, 2018) across advanced economies, including Switzerland. This transformative potential cannot be underestimated.
Switzerland requires proactive measures to address challenges and seize opportunities, successfully navigating this changing landscape. Two conditions are key for the country: accelerating digital transformation and investing in reskilling initiatives.
So, what’s the game plan? Swiss companies need to go beyond merely implementing new technologies. They require a fundamental redesign of business models, customer journeys, and operational processes to embed a “digital first” strategy. At the same time, reskilling the workforce is crucial to ensure that individuals possess the skills and knowledge necessary to thrive in the digital age. It involves investing in continuous learning programs, upskilling initiatives, and fostering a culture of innovation and adaptability.
Switzerland’s vibrant foundation ecosystem is making waves with over 13,000 active foundations, playing a pivotal role in education, research, culture, and social welfare sectors - as outlined in the Swiss Foundation Report 2021. Significantly, the aforementioned Report recognizes foundations as substantial catalysts for innovation in Switzerland. Therefore, it comes as no surprise that there has been a mounting focus on digitalization within Swiss foundations in recent years. While only a few have fully embraced digital transformation, many have acknowledged the paramount significance of incorporating new technologies into their operations and strategies. This observation is echoed on a global scale, as evidenced by a survey conducted by the Stanford Social Innovation Review, which found that 92% of Non-Profits worldwide believe that technology can significantly enhance their effectiveness in fulfilling their mission (Stanford Social Innovation Review, 2020).
In the era of rapid technological advancements, digitalization has emerged as a transformative force across industries worldwide. Switzerland finds itself navigating the opportunities and challenges brought forth by the digital age. Within this context, Swiss foundations are increasingly recognizing the need to embark on a journey of digital transformation.



The IBSA Foundation encourages the public to explore science-related subjects by promoting an accessible yet authoritative scientific culture, using language that resonates with everyone. It aims at communicating scientific topics in the simplest and most engaging way possible, while ensuring all information is rigorously fact-checked. The best way to further the Foundation’s mission is clearly through its website and social media channels. We developed a user-friendly and customizable HubSpot website, whose performance can be measured and optimized over time. To celebrate its 10 years of activity, the IBSA Foundation adopted the polyhedron as its symbol and logo. Drawing parallels to the faces of the geometrical form, the Foundation effectively engages with individuals through a variety of projects, initiatives, and formats, all working towards the shared goal of spreading knowledge on science, art, health and culture. By the same token, we implemented a social strategy to foster scientific research through accessible language and approaches, encouraging the public to delve deeper into science-related subjects.

+31.88% Page views

+26.73% Avg time on webpages
+20.98%
Click-through rate on newsletters







Source HubSpot – 2023 vs. 2022





Digital transformation for Non-Profits is not solely focused on generating revenue, but rather on utilizing solutions to maximize their potential impact and services. This transformation involves adopting new software and tools to streamline internal operations, harnessing the power of social media to expand their reach and engage with stakeholders, and utilizing data analytics to make strategic decisions. Agility, particularly in the digital realm, is of paramount importance for Non-Profit organizations. Being digitally agile means being proactive, flexible, and innovative in utilizing technologies to meet evolving needs. With this approach, foundations can seize opportunities to enhance their operations and better serve their beneficiaries. Organizations can employ digital channels to reach wider audiences, cultivate donor relationships, and generate support for their causes. By proactively planning and advocating for agility, Non-Profit organizations can pave the way towards a more agile future, ensuring that digital agility becomes an integral part of their operations and their way of navigating uncertainties, responding to evolving challenges, and seizing opportunities with adaptability and resilience.
By harnessing digital tools and technologies, Non-Profit organizations can collect and analyze data, gain insights into their operations and impact, and make informed decisions. With the right technological support, such as project management software, collaboration tools, and data platforms, organizations can optimize their operations and improve coordination among stakeholders spread across different locations. They can also streamline repetitive tasks across various domains, including administration, management, marketing, sales, and after-sales. These tools facilitate efficient communication, real-time data sharing, and seamless collaboration, enabling teams to identify critical areas for intervention and swiftly respond to emerging challenges.
foundations created in 2021: a new foundation for every day of the year



Non-Profits face several challenges when undertaking such innovation path, which can vary according to organizational size, resources, and the specific context in which they operate (some examples below). Overcoming these obstacles demands a strategic and comprehensive approach to digital transformation. It entails meticulous planning, inclusive stakeholder engagement, capacity building, and a nimble mindset to embrace emerging technologies.
Limited Resources: many Non-Profits operate with limited financial and human resources, which can be challenging when it comes to relying on professionals to address digitalization strategically, investing in technology infrastructure, acquiring digital skills, and managing ongoing maintenance and upgrades.
Resistance to Change: implementing digital transformation requires a shift in organizational mindset and a willingness to embrace change. Overcoming resistance requires effective change management strategies and clear communication about the benefits and importance of tech-driven transformation.
Data Security and Privacy: Non-Profits handle sensitive donor information and other confidential data. As a consequence, they need to invest in solid cybersecurity measures, train staff on data protection practices, and adhere to relevant data protection regulations.
Skill Gaps and Capacity Building: Non-Profits often lack the necessary skills within their teams to effectively implement and manage digital transformation initiatives. Capacity building efforts, such as training programs, partnerships with technology experts, or collaboration with IT service providers, can help utilize technology at its full potential.
Integration and Interoperability: Non-Profits often rely on multiple software applications and systems for different functions. Therefore, they need to carefully evaluate their technology infrastructure and invest in solutions that can integrate with existing systems or provide platforms to streamline operations.
By adopting an integrated strategy that encompasses all facets of their operations and activities, foundations can fully harness the potential of tech-driven transformation. To begin, foundations need to develop a clear and comprehensive digital strategy aligned with their mission and goals. This involves defining the desired outcomes, identifying priority areas for change, and establishing a roadmap for implementation. It is then essential to realize that digitalization is a driver of human capabilities, not a substitute. Technology should be used to enhance human experiences, empower stakeholders, and create meaningful connections.
Digital transformation is not a solitary endeavor. Foundations must prioritize capacity building and forge partnerships with technology experts to enhance their journey. Expert guidance is invaluable in crafting tailored strategies and providing ongoing support during the change process, in order to guarantee sustainable growth over time.

Effective change management is indeed crucial to instill a mindset that embraces innovation, recognizing it as a means to improve work quality and streamline operations. Additionally, foundations must invest in robust and scalable technology infrastructure, including cloud-based solutions and data security measures.
Outsourcing this process can ensure success, as opposed to haphazardly attempting to keep up with the times, which can lead to dissatisfied staff and inconclusive outcomes. Opting for a strategic partner with comprehensive skills and extensive networks can provide end-to-end support, encompassing change management, software development, and the strategic governance of all digital and analog touchpoints.
www.ated.ch













After five decades of activity, ated realized the need to revitalize in order to truly embody its vision of growth and adaptability. We conducted a comprehensive analysis of the industry, assessed the association’s value proposition and formulated a rebranding strategy that effectively communicated ated’s intentions and scope. A change in ated’s acronym from “Associazione Ticinese Elaborazione Dati” (Data Processing Association of Ticino) to “Evoluzione Digitale” (Digital Evolution), was the first step in conveying its commitment to empowering individuals and organizations to thrive in the ever-changing digital landscape. This transformation is now firmly embedded within ated’s brand system and is reflected in the new digital ecosystem we created. Associations must be able to communicate in a clear and straightforward manner, and by developing a user-friendly HubSpot website that presents its message clearly and directly, we delivered a seamless experience for sponsors and members. Optimizing contact management and automating time-consuming tasks enabled us to facilitate personalized communication between ated and its partners, allowing them to focus on high-value activities.










Encompassing all the essential information

Enabled by a cohesive brand system

For contact management optimization

We made an assessment of how to better achieve a whole new level of efficiency and connectivity to help Croce Rossa Ticino engage with existing and potential donors and volunteers, who represent the beating heart of the association. We defined an approach to reposition the association as the Ticino Canton branch of the Swiss Red Cross and evaluated how to improve its internal decision making process and external communication with its audience. In practice, this has resulted in a comprehensive reimagining of the website’s architecture and the integration of the HubSpot CRM platform into its operations: revolutionizing contact management and transforming the association’s relationship with the public (previously bogged down in paper-based and offline communication methods). Branding involved a new refreshed image for Croce Rossa Ticino, aligning it with the Swiss Red Cross. The result is a cohesive user interface that resonates with the audience, reinforcing the association’s commitment to its mission.
+191.38% Newsletter subscribers


+19.89% Sessions
Source HubSpot – 2023 vs. 2022


Digital transformation offers significant benefits for foundations operating in Switzerland. By leveraging technology, Non-Profits can streamline their processes, increase efficiency, and reduce administrative burdens. Data-driven decision making allows foundations to measure and evaluate impact more accurately, leading to more effective grantmaking strategies.

Digital fundraising campaigns and personalized donor experiences provide opportunities to attract and retain donors, ensuring a sustainable flow of funding. Moreover, digital transformation enhances transparency, accountability, and trust by providing real-time updates on activities, financials, and impact.
It also opens up avenues for collaborations and partnerships on a global scale, fostering knowledge exchange and innovation. In the Swiss context, where philanthropy is strong and the sector is evolving, embracing technological advancement positions Non-Profits at the forefront of social change. By harnessing the power of innovation, foundations in Switzerland can maximize their potential, create lasting positive change, and contribute to a more inclusive and sustainable society. •
At Ander Group, we have supported numerous Swiss foundations on their digitalization journey, prioritizing a human-centered approach that promotes the value of people and strategic thinking. Our mission is to guide these foundations in overcoming cultural barriers and equipping them with the necessary tools to recognize the significance of embarking on this transformative path.

“With our deep experience in the Non-Profit sector, through partnerships with organizations like the IBSA Foundation, Croce Rossa Ticino, La Fonte Foundation, and ated, we understand the unique needs of this sector. Partnering with Ander Group ensures that your investments achieve tangible results, while enhancing human capital through valuable activities.”
Florian Anderhub Chief Vision Officer Ander Group
of Non-Profits agree that technology improves efficiency and mission impact
We devised a comprehensive strategy to guide Sinomedica in realizing its mission of becoming the worldwide point of reference for science-based acupuncture. Utilizing multiple touchpoints, we strategically raised awareness about medical acupuncture, while also assisting Sinomedica with expansion abroad. Strategic planning always guides our marketing initiatives. Through market and competitor analysis, we identified digital landscape opportunities and risks along with buyer personas. We designed a purpose-built website architecture that improved the user experience and Google positioning. Google Ads drove interest, reaching a ROAS of up to 300%. With our social strategy,


we maximized channel functionalities with dedicated editorial calendars. We designed a completely new corporate image to convey the company’s vocation for science-based medical acupuncture. “Come to the point” was developed as Sinomedica’s new claim, becoming the fil rouge that guided both brand awareness campaigns and visual identity, allowing the company to present integrated, effective brand communication. The resulting synergy between the various activities led to an increase in turnover in just a few months. By analyzing key metrics and tracking the impact of our strategies, we consistently optimize our work to maximize its effectiveness and further enhance Sinomedica’s impact.

2Mln Ads impressions 502 Leads in 3 months












9.14% Form conversion rate



“The strategy devised by the Ander Group team allowed us to quickly achieve a search engine ranking for the new website, boost the brand’s online presence and immediately increase patient numbers at all our clinics in Switzerland.”
 Marc Aubert Chief Marketing and Communication Officer
Marc Aubert Chief Marketing and Communication Officer

SIX Digital Exchange (SDX), part of SIX Group, offers the first ever fully regulated digital asset exchange. SDX strives to provide a reliable infrastructure to enable liquidity, transparency, efficiency and the financial industry of tomorrow. The SDX case reflects a matter we’re passionate about: striking the balance between form and function. Before we stepped in, SDX’s graphics – such as its logo – were geared chiefly to esthetics, with no clear guidelines on everyday use. We focused on creating suitable templates to meet the various communications needs,

both offline and online (social media, presentations, business cards, website, mobile, etc.). And that’s not all. We also distinguished the core brand (SDX) from a product application (Web3), using the distinctive colors magenta and blue. The real added value for the SDX team lies in improved communications management and the simplification of everyday activities, all thanks to precise guidelines, a consistent brand system, and a shared, comprehensive tool for graphic assets management (Frontify).
Communications Manager, SIX Digital Exchange
“Ander Group has further shaped and refined our brand identity by bringing clarity to our brand assets and empowering us to create communication materials consistent with our visual identity.”
Nina Coelho Antunes Senior Marketing















repeople is the natural evolution of a project that started out as Borsa Immobiliare Ticino (BIT) [Ticino Real Estate Exchange], a beacon for professionals and companies in the real estate world for eight editions. Faced with an increasingly international community and eager to expand its reach beyond the boundaries of the Canton of Ticino, our client needed a brand that would express its new intentions, along with a new value proposition. We strategically redefined the mission, vision and values, and mapped out the communications plan and storytelling. The new value proposition — “the network for the sustainable future of real estate” — was designed to identify an expert and responsible community, mindful of the role of real estate in an economic and social landscape
where the environment and climate change are number one priorities. At the same time, this process involved creating a design and brand system that would embody the new identity while serving a practical purpose in managing offline and online communication. repeople, whose core business is network and contact management, benefited enormously from the HubSpot CRM Platform rollout, hosting all its marketing operations — website, email marketing, workflows and automations, and contact database management — in just one place. We also natively integrated Eventbrite — one of the world’s most popular ticketing systems — into HubSpot to keep track of ticket purchases directly in the HubSpot database, with a view to supporting community profiling activities.








“The transition from BIT to repeople marked a significant milestone for us. We are now poised to accomplish our mission of connecting people through sustainable networking practices, not just by maintaining a cohesive identity but also by implementing efficient and streamlined internal processes.”
Paolo Caspani CEO & Founder
+170% Sessions
Source HubSpot – Q1 2023 compared with Q4 2022
86% New visitors
+365% New appointments requests
Since the physiotherapeutic landscape in Switzerland is subject to a number of legal restrictions preventing proactive advertising in this field, we aimed at positioning Il Centro at an organic level, which meant designing a new, effective and communicative website. In-depth content design was necessary to raise brand awareness. In parallel, we developed a well-defined visual identity, giving new life and consistency to the company logo and colors. We redesigned the website architecture so as to effectively communicate Il Centro’s vision: all round health
specialists. The new website brings together the individual service lines by encompassing them all under one umbrella, accompanying users through the website as if they were walking through the rooms at the various locations, up to the moment of booking via a tracked form. In order to monitor the progress of the work done over time, and to optimize it, we implemented an ad hoc tracking system aimed at evaluating both the outcomes of the long-term SEO strategy and the number of visitors and conversions on the site.

“With Ander Group’s support, we are able to showcase the full spectrum of our services, extending well beyond physiotherapy, as we strive to cater to our clients’ overall well-being. This enables us to effectively convey our authentic identity, capturing the attention of a broader audience and expanding our customer base.”


































 Mirco Bianchi Founder and Owner, Il Centro
Mirco Bianchi Founder and Owner, Il Centro


































For Ander Group, the focus is not simply on creating meaningful brands, but on ensuring long-term business growth based on performance optimization, timely performance reviews and results-oriented consulting.
We support you in the digitization of marketing, sales and after-sales operations to automate low valueadded activities, identify new revenue streams and foster business continuity. Digital agility is no longer optional, but the means to affirm human capabilities.
Since 2006, we serve an international client base - designing brand ecosystems, driving measurable business results, and growing long-lasting relationships.
Industries
Finance & Banking
Hospitality & Leisure
Healthcare
Business Consulting
Real Estate
E-commerce & Retail
Non-Profit

















We provide a highly qualified team with multifaceted competences always striving for the right balance between form and function – because Performance Branding can only be achieved through data-driven optimization.
Scope
Based on an analysis of the starting situation and the market context, we define the project scope, targets and KPIs and the differentiating components of the brand’s identity (values, mission, vision and USP).
Activate
We establish the ecosystem in all its digital and non-digital forms in order to initiate the brand experience. We activate the most appropriate analytical and operational tools to achieve targets, and we implement the marketing, sales and after-sales processes, from configuring accounts to drafting editorial plans and launching campaigns.
Optimize
Continuous optimization brings results and growth. The performance review is not one single event but involves regular cycles of feedback and improvement. It isn’t a static assessment but a continuous study to improve performance and achieve the desired results.
Brand Idea
Architecture
Unique Selling Proposition
What is the benefit
Mission Vision
Positioning
Branding
Benchmark
Value Proposition
User Personas
Design System
Analytics Cockpit
Tone of Voice
Business Model Verbal/Visual Identity
Experience Design
SEO Writing
Editorial Planning
Goals Setting SEO Analysis
Funnel Design
Reporting
Performance
Action Plan
Keyword Analysis
Database Qualification
Target Definition
Workflow Automation






The HubSpot CRM Platform allows us to centralize all digital touchpoints in order to track and measure all interactions of your contacts database to ensure you’ll always attain the highest digital potential all along the buyers’ journey.
Ecosystem.hubspot.com






With HubSpot, thanks to its Marketplace app, interactions from third-party platforms can also be sent to a single database. This provides an increasingly detailed mapping of the customer journey: from marketing to sales and post-sales, streamlining the decision-making process.
Since 2012, HubSpot Academy’s mission is to transform how people and businesses grow, offering various types of online courses for the digital age: marketing, sales, service, web design, web development and data privacy, to name just a few. Holders of HubSpot licenses can therefore benefit from free continual online training on these topics, and obtain the corresponding certification.
Inform and promote
Social Media Form Blog CMS Website Landing Pages
Newsletter Analytics Paid Campaigns Call-To-Action
Account-Base Mktg Marketing automation
Tools that help you reach your audience at the right time and in the right place
Manage and convert
Lead rotation Sales automation Goals Quotes
Forecasting Deals Task mngmt Pipeline
Rep performance Meeting scheduling
Powerful sales software to help you close more deals, deepen relationships, and manage pipelines more effectively
Support and delight
Shared inbox Team email SLAs Tickets
Live chat
Report Feedback Survey
Customer portal Help desk automation
This after-sales platform helps you improve your customers’ experience
Contact e.g. Albert Einstein mc2@gmail.com
Contacts DB
At Goodcode, software development is based on three foundation stones: integration, automation and transformation, making it a means of giving new value to human activity and of creating new earning opportunities.
For companies that want to continue to grow, freeing themselves from repetitive and low value-added operations is a must, even more so in an uncertain macroeconomic climate. Assigning certain mechanical, repetitive tasks to a machine is an excellent solution to eliminate the margin of error during accounting or production.
Artificial intelligence and machine learning are opportunities to create advanced software solutions that enable applications to learn from data, so continuously improving their performance.
What underpins “good code”? Goodcode was founded partly in response to this question, differentiating itself through its software solutions that integrate perfectly with existing ecosystems, translating their languages, enabling cross-cutting communication, and enhancing their functionality.
Transformation
The digital world is as fascinating as it is complex; Goodcode is a strategic partner able to guide companies step by step through digitalization, optimizing processes, without overlooking any business aspects: from migrating to the cloud and implementing security measures, to user profiling and analysis in order to optimize costs.
Integrating our software with pre-existing digital ecosystems means the creation of fluid, interactive connections, ensuring that new solutions collaborate synergistically with the existing technological infrastructure.
The blockchain is like a shared digital accounting ledger that offers companies a secure way to record transactions and simplify business processes, reducing risk and increasing efficiency.
In a world where technology is central to business operations, cybersecurity has become fundamental. It is companies’ digital defense, designed to protect digital resources from external threats.


















The upwards arrow, the open A, the upper-case font. At first glance, these may seem like minor changes. But just as a book’s cover doesn’t tell the whole story, so, if we take a closer look at our rebranding, we’ll see there’s far more than meets the eye. There’s the process of self-analysis, which takes time - we debated it among ourselves, we considered our path forward and we set our future direction. There’s the understanding that growth requires change, as well as experimentation, research and experience. There’s demonstrating through action, not just with words, what
our approach means, making it our signature methodology. There’s our conviction that, by first improving ourselves, we can give our customers the most complete and effective service possible. There’s a predefined creative context and a new graphics layout. And there was a lot of coffee

Our logo thus represents our desire for data-driven growth, our propensity to evolve and remain open to innovation, and our maturity and experience gained over two decades of business. In the end the arrow, the open A and the upper-case font weren’t such minor changes after all.



“We are not just about creating logos, we are about telling stories. In this case, we told our own. Working on ourselves is a good way to show clients how we like to do things.”
 Florian Anderhub Chief Vision Officer
Florian Anderhub Chief Vision Officer
Our rebranding involved the entire Group, highlighting the abilities of a diverse team that brings together multidisciplinary skills: technological, creative and strategic, always striving for the perfect balance between form (Branding) and function (Performance): Performance Branding. When these two worlds, seemingly so far apart, exist in harmony they drive “results stories”, in which brands aren’t just ends in themselves but are linked to performance, with a view to constant and sustainable growth. This concept is expressed in the new claim “Growth by Design”. Specifically, “Growth by Design” is achieved by transforming company processes in the HubSpot CRM Platform.
We are proud to be a HubSpot Platinum Partner, recognizing the great potential and added value of integrated business management. This technology enables user interactions to be recorded, opening the door to effective segmentation and to the definition of a database for all company operations, from marketing to sales and postsales. Branding and storytelling, as part of the process, also play a key role by helping to communicate information in a consistent, recognizable and shared way. Using the rhetorical logic of a well-structured story, then, creates a common emotional thread that arouses the public’s interest and facilitates its understanding.
